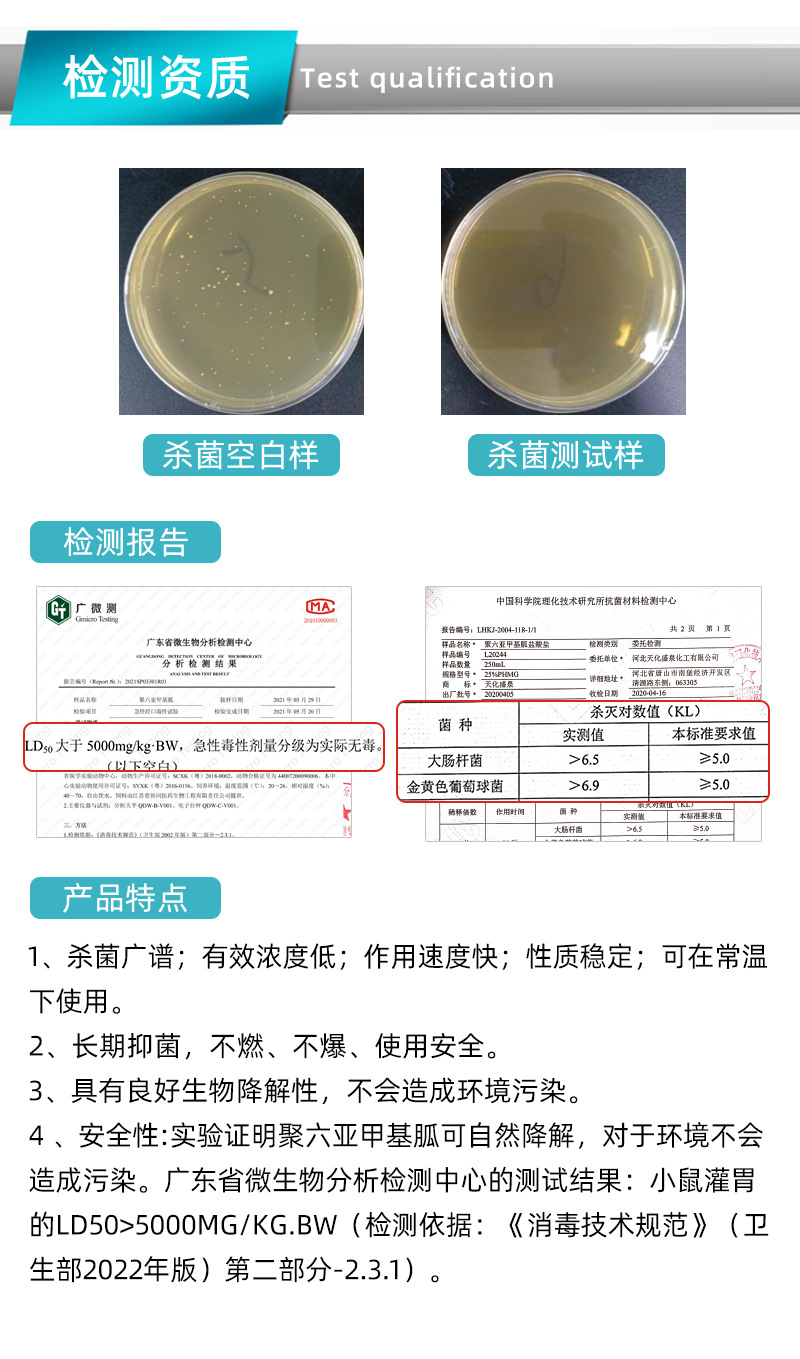
undefined

1688以外のサイト、現地商品市場から弊社が独自にリサーチした商品のご提案を行います。 また、お取り組み先にご覧頂きやすいように「G/M」が付いた品番はこちらから検索ください。
1688.comは中国で生産され、流通している商品を扱うBtoB卸サイトとなります。お客様が弊社サイト内にて仕入処理をされても、日本国内の法律に則り、日本への輸入ができない商材もあり、その場合弊社でも仕入れの手配が出来ません。その際はシステム上で、自動的に注文削除となってしまう事を、恐れ入りますがご了承願います。
※単価についての注意事項: 船便の単価が適用されるには、今回の仕入において(他の商品も含めた)、消費税抜きの仕入総合計金額が20万円以上の場合となります。 総合計が20万円未満の場合はシステムで自動的にOCSの単価が適用されます。
{{ variable.name }}